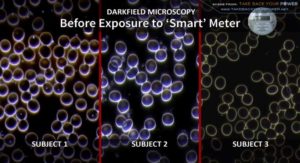
pametna brojila zračenje

Zračenje pametnih brojila uzrokuje velike zdravstvene probleme – ANALIZA KRVI
Izlaganje zračenju pametnih brojila uzrokuje mnoge čudne i nepoznate zdravstvene probleme. Ljudi koji su izloženi ovoj vrsti zračenja počinju gubiti interes za život, entuzijazam i radost. Doživljavaju tjeskobu i … Nastavi čitati Zračenje pametnih brojila uzrokuje velike zdravstvene probleme – ANALIZA KRVI